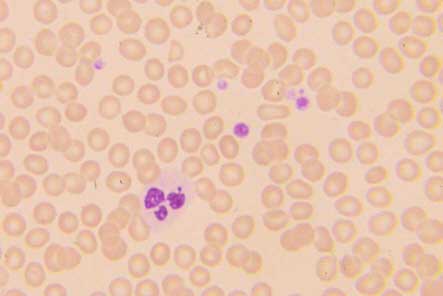

EDTA-Pseudothrombozytopenie
Bei 1% aller Blutproben induziert das Antikoagulans EDTA eine Agglutination der Thrombozyten oder eine Anlagerung an Granulozyten. Es handelt sich um ein in vitro Phänomen und ist die häufigste häufigste Ursache erniedrigt gemessener Thrombozytenwerte. Zählt man die Thrombozyten in mit Zitrat oder Heparin antikoaguliertem Blut oder mikroskopiert man, ist dieses Artefakt leicht erkannt. Sein Ausschluss steht am Anfang der Diagnose jeder Thrombozytopenie.
Hereditäre Thrombozytopenien
Angeborene Thrombozytopenien sind selten. Sie werden durch den Pädiater diagnostiziert und behandelt. Nur wenige, mild ausgeprägte Fälle kommen erst im Erwachsenenalter zur Vorstellung. Beim Bernard-Soulier-Syndrom (ICD10 D69.1) sind charakteristischerweise die meisten Thrombozyten im Blutausstrich vergrössert, bei der ITP nur einige wenige. Wenn die Familien-Anamnese nicht erhoben wird, ist die Verwechslung mit einer ITP besonders leicht (Abbildung 5). Beim Fechtner- (ICD10 D69.4) und Sebastian-Syndrom (ICD10 D69.4) und bei der May-Hegglin-Anomalie (ICD10 D69.4) sind die Thrombozyten ebenfalls vergrößert. Hier zeigen Granulozyten zusätzlich charakteristische Einschlusskörper. Beim Wiskott-Aldrich-Syndrom (ICD10 D82.0) und bei der X-chromosomalen Thrombozytopenie (ICD10 D82.0) sind die Thrombozyten dagegen klein. Beim Radius-Aplasie-Syndrom ist der Skelett-Befund charakteristisch (ICD10 Q87.2). Beim Gray-Platelet Syndrom fehlen die a -Granula, die Thrombozytenzahl ist vermindert und im nach Pappenheim gefärbten Blutausstrich fehlt den Thrombozyten die rötlich-blaue Granulierung (ICD10 D69.1). Bei der Fanconischen Anämie (ICD10 D61.0), dem Schwachmann-Diamond-Syndrom (ICD10 D61.0) und der Amegakaryozytären Thrombozytopenie (ICD10 D69.4) entwickelt sich in der Regel eine Knochenmarkaplasie und Zytopenie aller Zellreihen. Für diese und weitere seltene angeborene Thrombozytopenieformen sei auf die Lehrbücher der Hämatologie und Pädiatrie verwiesen.
Schwangerschaftsassoziierte Thrombozytopenien
6-8% aller gesunden, schwangeren Frauen können im letzten Trimenon eine leichte Thrombozytopenie ohne klinische Relevanz entwickeln (sog. Gestations-Thrombozytopenie, ICD10 D69.5). Die Ursache dieses Phänomens ist nicht bekannt. Die Thrombozytenzahl liegt in der Regel über 70.000/m l, während bei ITP-Patientinnen die Werte meist niedriger sind. Die Gestations-Thrombozytopenie ist asymptomatisch, nicht mit einer Thrombozytopenie des Kindes assoziiert und verschwindet nach der Geburt wieder. Differentialdiagnostisch muss an eine Thrombozytopenie bei HELLP-Syndrom (ICD10 O41.1), an eine Verbrauchskoagulopathie (ICD10 D65) und die Eklampsie (ICD10 O14.9)gedacht werden.
Neonatale Alloimmunthrombozytopenie (ICD10 P61.0)
Die neonatale Alloimmunthrombozytopenie wird beim Kind durch eine Immunisierung der Mutter gegen Antigene der Thrombozyten des Kindes ausgelöst, die die Thrombozyten der Mutter nicht tragen. Zumeist sind die Antikörper gegen das humane Plättchen-Antigen HPA-1a auf dem Glykoprotein IIIa gerichtet. 1-2% aller Schwangeren sind HPA-1a negativ. 10% der HPA-1a-negativen Schwangeren mit einem HPA-1a-positiven Fetus entwickeln Antikörper. Nach diaplazentarem Transfer der Antikörper kommt es zur Thrombozytopenie beim Kind. Die neonatale Alloimmunthrombozytopenie führt bei 1 von 5000 Neugeborenen zu einer Blutungsneigung. Im Gegensatz zum pathogenetisch ähnlichen Morbus haemolyticus neonatorum ist meist schon das Erstgeborene betroffen. 10% der Neugeborenen zeigen Petechien. Zum Teil kommt es bereits intrauterin zu Blutungen; besonders gefürchtet sind intrazerebrale Blutungen.
Eine Untersuchung der Thrombozytenantigene des Vaters und eine genetische Beratung sind notwendig. Hatte eine Mutter bereits ein betroffenes Kind dann sollte bei einer erneuten Schwangerschaft (vom selben Vater!) durch Cordozentese der Antigenstatus des zweiten Kindes festgestellt werden. Bei einem HLA-1a positiven Kind ist das erneute Blutungsrisiko extrem hoch (90%). Zur Therapie des Kindes werden der Mutter Steroide und i.v. Immunglobuline verabreicht; das Kind erhält bei ausgeprägter Thrombozytopenie intrauterine Thrombozytentransfusionen. Die Behandlung ist nur in einigen Zentren möglich.
Posttransfusionelle Purpura (ICD10 D69.5)
1 Woche nach Transfusion von Blutprodukten entwickeln die Patienten - meist Frauen mit vorangegangenen Schwangerschaften - eine schwere Thrombozytopenie mit ausgeprägter Blutungsneigung. Die Patientinnen sind HPA-1a-negativ und haben dann Antikörper gegen das HPA-1a Antigen entwickelt. Obwohl ihre Thrombozyten das Antigen nicht tragen, werden sie zerstört. Der Pathomechanismus ist nicht bekannt. Möglicherweise binden zirkulierende Immunkomplexe aus Antikörpern und Plättchenglykoprotein an die Thrombozyten oder die Transfusion löst die Bildung eines Autoantikörpers aus, der auch mit den autologen HPA-1a-negativen Thrombozyten reagiert. In vitro können HPA-1a-negative Thrombozyten lösliches Antigen aus dem Plasma HPA-1a-positiver Patienten absorbieren. Auch eine "pseudospezifische" Alloantikörper-Reaktion ist möglich, die sich dann gegen die autologen Thrombozyten richtet. Nach 3-5 Wochen bildet sich die Thrombozytopenie wieder zurück. Die Therapie der häufig stark ausgeprägten Blutungsneigung besteht in der Gabe von Steroiden und Immunglobulinpräparaten.
Medikamenteninduzierte Thrombozytopenie (ICD10 D69.5)
Diese wichtigste Differentialdiagnose der ITP kann nur durch die wiederholte Anamnese ausgeschlossen werden. Ein Medikament kann als Auslöser der Thrombozytopenie betrachtet werden, wenn folgende Kriterien erfüllt sind:
-
Das Medikament wurde eingenommen bevor die Thrombozytopenie auftrat und nach Absetzen des Medikamentes normalisierte sich ihre Zahl wieder.
-
Das Medikament wurde zusammen mit anderen Medikamenten eingenommen als die Thrombozytopenie auftrat. Die Thrombozytopenie erholte sich nach Absetzen des Medikamentes, obgleich die anderen Medikamente weitergeführt wurden.
-
Andere Ursachen einer Thrombozytopenie wurden ausgeschlossen.
-
Eine wiederholte Exposition führt zur erneuten Thrombozytopenie.
Obwohl die Kriterien 1-3 die Diagnose nur wahrscheinlich machen, wird nur in ausnahmsweise bei lebenswichtigen Medikamenten ein Re-Expositionsversuch durchgeführt und damit die Diagnose definitiv gesichert. Der Verdacht auf eine medikamenteninduzierte Thrombozytopenie kann durch den immunologischen Nachweis medikamentenabhängiger antithrombozytärer Antikörper bestätigt werden. Dies in vitro Verfahren ist jedoch beschränkt. Wenn die Immunreaktion durch spezielle Metabolite vom Individuum ausgelöst wurde, versagt es. Nach Absetzen des Medikamentes erholt sich die Thrombozytenzahl meist innerhalb von 7 Tagen wieder. Der Nutzen einer zusätzlichen Therapie mit Steroiden oder Immunglobulinen ist umstritten.
Die medikamenteninduzierte Thrombozytopenie setzt eine vorherige Immunisierung des Patienten voraus. Bei der Behandlung mit GP IIb/IIIa-Inhibitoren kommt es jedoch auch bei erstmaliger Anwendung in < 1% der Fälle zu einer reversiblen Thrombozytopenie. Ursächlich vermutet man präformierte Antikörper gegen Epitope auf dem GP IIb/IIIa-Rezeptor, die erst nach Bindung des Inhibitors für eine Immunreaktion zugänglich werden. Warum diese Antikörper präformiert, d.h. schon vor der ersten Gabe des GP IIb/IIIa-Inhibitors vorhanden sind, ist nicht bekannt. Die Diagnose ergibt sich aus der offensichtlichen zeitlichen Assoziation. Ohne manifeste Blutungen wird keine spezifische Therapie empfohlen, sonst können Thrombozytenkonzentrate gegeben werden.
Bei der Heparin-induzierten Thrombozytopenie kommt es durch Antikörper gegen Antigene des Plättchenfaktors 4, die erst nach Bindung von Heparinoiden zugänglich werden, zur Immundestruktion und Aktivierung der Thrombozyten. Die Ausbildung von Thrombosen und Embolien steht klinisch im Vordergrund, bei starker Thrombozytopenie haben die Patienten jedoch auch eine ausgeprägte Blutungsneigung. Die Diagnose ergibt sich aus der Anamnese und den klinischen Befunden.
Das zur Thrombozytopenie – Bekämpfung gentechnologisch hergestellte Zytokin "Megakaryozyten Wachstum und Entwicklungfaktor" oder auch Thrombopoetin erzeugte eine besondere Form der schweren Thrombozytopenie. Ein Antikörper gegen ein unter dem Einfluss des Zytokins entstandenes Neoantigen des Rezeptors machte ihn wirkungslos auch für das körpereigene Wachstumshormon der Megakaryozyten. Die Beobachtung stoppte die weitere Entwicklung dieses wichtigen Wachstumsfaktors der Blutbildung.
Eine aktuelle Liste von Arzneistoffen, für die medikamentenassoziierte Thrombozytopenien beschrieben wurden findet sich unter:
http://moon.ouhsc.edu/jgeorge/database.html
